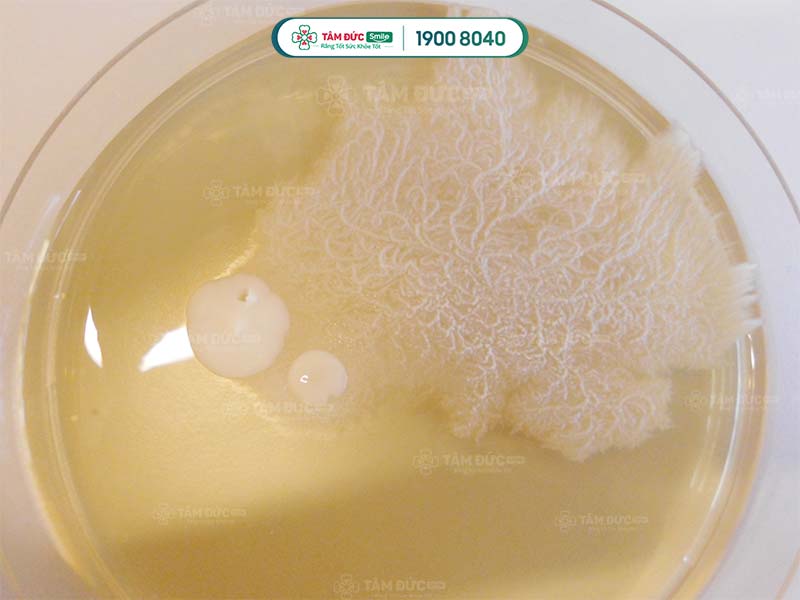

BẬT MÍ DẤU HIỆU NHẬN BIẾT NẤM MIỆNG Ở TRẺ SƠ SINH VÀ CÁCH ĐIỀU TRỊ DỨT ĐIỂM
1. Nguyên nhân trẻ sơ sinh mắc bệnh nấm miệng
Tác nhân chính gây ra nấm miệng ở trẻ sơ sinh là do nấm Candida albicans. Nấm này thường tồn tại trong cơ thể đến khi sức đề kháng của trẻ suy giảm, nấm phát triển mạnh và gây bệnh.
Nguyên nhân nấm miệng bùng phát ở trẻ sơ sinh là do:
- Lạm dụng thuốc kháng sinh: Việc lạm dụng thuốc kháng sinh có thể làm mất cân bằng hệ vi khuẩn trong cơ thể của trẻ, tạo điều kiện cho nấm Candida phát triển.
- Sức đề kháng của trẻ kém: Hệ miễn dịch của trẻ còn non yếu, dễ bị nhiễm trùng và các bệnh lý khác. Khi sức đề kháng của trẻ giảm, nấm Candida cũng dễ dàng phát triển và gây bệnh.
- Bé bị nhiễm nấm từ mẹ: Mẹ bị nấm sinh dục trong thời gian mang thai hoặc đang cho con bú có thể lây sang trẻ.
- Vệ sinh răng miệng kém: Khi trẻ bú mẹ hoặc uống sữa, cặn sữa bị đọng lại trong miệng. Nếu không được vệ sinh sạch sẽ, cặn sữa tạo điều kiện cho nấm Candida phát triển. Bên cạnh đó, việc sử dụng núm vú, ti giả, đồ ngậm nướu không được vệ sinh sạch cũng có thể là nguyên nhân gây nấm miệng ở trẻ sơ sinh.
Nấm Candida
2. Dấu hiệu nhận biết nấm miệng ở trẻ sơ sinh theo từng giai đoạn
2.1. Giai đoạn 1: Nấm miệng ở trẻ sơ sinh giai đoạn nhẹ
Ở giai đoạn này, trẻ có thể có các triệu chứng sau:
- Xuất hiện các mảng trắng, mịn, dính ở lưỡi, nướu, má, môi, hoặc vòm miệng.
- Mảng trắng có thể dễ dàng bị cạo ra, để lại vết đỏ hoặc chảy máu.
- Trẻ có thể quấy khóc, bỏ bú.
2.2. Giai đoạn 2: Nấm miệng ở trẻ sơ sinh giai đoạn nặng
Ở giai đoạn này, bệnh có thể lây lan sang các bộ phận khác của cơ thể, gây ra các triệu chứng sau:
- Mảng trắng lan rộng hơn, có thể bao phủ toàn bộ miệng.
- Mảng trắng trở nên dày hơn, khó cạo ra.
- Trẻ có thể bị sốt, khó nuốt, nôn trớ, hoặc ho.
Một số trường hợp hiếm gặp, bệnh nấm miệng có thể lây lan sang đường tiêu hóa, gây tiêu chảy, đau bụng, hoặc nôn mửa.


ĐẶT HẸN NGAY HÔM NAY ĐỂ ĐƯỢC:
► Khám và tư vấn miễn phí
► Miễn phí chụp film cùng với máy Conebeam CT trị giá 700K
► Miễn phí quét mẫu hàm công nghệ ITERO trị giá 3 triệu
► Hỗ trợ trả góp 0% lãi suất
3. Nấm miệng ở trẻ sơ sinh có tự khỏi được không? Cần điều trị như thế nào?
3.1. Lời khuyên từ chuyên gia
Nấm miệng ở trẻ không quá nguy hiểm nếu được phát hiện và xử lý sớm. Bệnh lý này không thể tự khỏi mà cần điều trị bằng thuốc kháng sinh chống nấm. Trong giai đoạn đầu, nếu điều trị đúng cách, trẻ sẽ khỏi bệnh sau 1-2 tuần.
Khi phát hiện trẻ có dấu hiệu nấm miệng, ba mẹ cần đưa trẻ đến cơ sở y tế uy tín để khám và điều trị kịp thời. Quý khách không nên tự ý mua thuốc trị nấm để bôi lên miệng bé khi chưa hỏi qua ý kiến của bác sĩ.
Ngoài ra, ba mẹ cần lưu ý một số vấn đề sau:
- Không nên lạm dụng nước muối sinh lý để vệ sinh miệng cho trẻ, vì có thể gây tổn thương lưỡi của trẻ.
- Không nên sử dụng mật ong để đánh tưa lưỡi cho trẻ, vì mật ong có tính nóng và dùng nhiều có thể gây ngộ độc.
3.2. Điều trị nấm miệng ở trẻ sơ sinh bằng thuốc
Đối với trẻ em bị nấm miệng, thuốc kháng nấm bôi miệng là lựa chọn ưu tiên trong giai đoạn đầu điều trị. Nếu thuốc bôi không đáp ứng, bác sĩ có thể chỉ định dùng thuốc kháng nấm toàn thân đường uống để tiêu diệt nấm và ngăn ngừa tái phát.

Chữa nấm miệng ở trẻ sơ sinh cần thực hiện từ từ để tránh bé bị nôn trớ
3.2.1. Các loại thuốc kháng nấm
- Miconazole 2%: Một trong những thuốc kháng nấm phổ rộng, có thể dùng được cho trẻ từ 4 tháng tuổi đến 2 tuổi. Thuốc có dạng dưới dạng gel, dùng để bôi tại chỗ bị nấm. Cơ chế tác dụng của miconazole là ngăn chặn sự tổng hợp ergosterol, một thành phần quan trọng của màng tế bào nấm.
- Nystatin: Là một loại thuốc kháng nấm được sử dụng để điều trị nhiễm trùng nấm men, bao gồm nấm miệng ở trẻ sơ sinh và trẻ nhỏ. Nystatin được bào chế dưới dạng dung dịch, kem bôi hoặc viên nén. Đối với trẻ sơ sinh và trẻ nhỏ, bác sĩ thường sử dụng dạng dung dịch để rơ lưỡi. Cơ chế tác dụng của nystatin là liên kết với sterol, một thành phần quan trọng của màng tế bào nấm, làm phá huỷ màng tế bào nấm.
Sau khi bác sĩ chỉ định thuốc bôi trị nấm phù hợp cho trẻ, Quý khách hãy thực hiện theo các bước sau:
- Bước 1: Rửa sạch tay với xà phòng và nước ấm.
- Bước 2: Pha thuốc theo hướng dẫn của bác sĩ.
- Bước 3: Dùng gạc hoặc bông gòn mềm thấm thuốc và thoa đều lên các vùng bị nấm trong miệng trẻ, bao gồm lưỡi, má trong, nướu răng,...
- Bước 4: Giữ thuốc trong miệng trẻ khoảng 20 phút trước khi cho trẻ ăn hoặc bú.
Lưu ý:
- Khi bôi thuốc, Quý khách cần nhẹ nhàng để tránh làm trẻ khó chịu, nôn trớ.
- Quý khách nên bôi thuốc trước bữa ăn để trẻ không bị nôn trớ.
3.2.2. Lưu ý khi dùng thuốc nấm miệng ở trẻ sơ sinh
- Chỉ dùng thuốc kháng nấm khi có chỉ định của bác sĩ.
- Tiếp tục dùng thuốc theo hướng dẫn của bác sĩ ngay cả khi các triệu chứng đã hết.
- Vệ sinh miệng cho trẻ đều đặn.
- Dùng miếng gạc mềm thoa thuốc đều cho trẻ.
- Cẩn thận khi sử dụng thuốc dạng gel ở trẻ sơ sinh.
- Không cậy những đốm trắng trong miệng hoặc lưỡi trẻ.
- Không tự ý sử dụng các bài thuốc dân gian cũng như uống thuốc kháng sinh.
4. Phòng ngừa tái nhiễm nấm miệng ở trẻ sơ sinh
Dưới đây là một số biện pháp giúp ngăn ngừa tái nhiễm nấm miệng ở trẻ sơ sinh.

Vệ sinh sạch sẽ đồ chơi của bé
4.1. Vệ sinh khoang miệng cho trẻ
Đây là biện pháp quan trọng nhất để ngăn ngừa nấm miệng tái phát. Mẹ nên vệ sinh răng miệng cho trẻ ít nhất 2 lần/ngày bằng nước muối sinh lý hoặc nước sạch. Mẹ có thể dùng bông gòn thấm nước muối sinh lý lau sạch miệng cho trẻ.
4.2. Vệ sinh đồ dùng cá nhân của trẻ
Mẹ cần thường xuyên vệ sinh núm vú giả, bình sữa, đồ chơi,... của trẻ bằng nước rửa chén hoặc nước ấm pha với giấm. Ngoài ra, mẹ cũng nên thay núm vú giả, bình sữa, đồ chơi của trẻ thường xuyên.
4.3. Vệ sinh cơ thể cho trẻ
Mẹ cần thường xuyên tắm rửa cho trẻ bằng nước ấm, sạch. Chú ý lau sạch các nếp gấp trên da của trẻ để tránh tạo ra môi trường ẩm ướt, tạo điều kiện cho nấm phát triển.
4.4. Tăng cường sức đề kháng cho trẻ
Mẹ cần cho trẻ ăn uống đầy đủ chất dinh dưỡng, đặc biệt là các loại thực phẩm giàu vitamin và khoáng chất. Ngoài ra, mẹ cũng nên cho trẻ bú sữa mẹ hoàn toàn trong 6 tháng đầu đời.
>>> Xem thêm: Nấm miệng có lây không? Bật mí cách phòng tránh lây nhiễm nấm miệng cực hiệu quả
Trên đây là những thông tin cơ bản về cách điều trị nấm miệng ở trẻ sơ sinh. Hy vọng bài viết này sẽ giúp ích cho các bậc cha mẹ trong việc chăm sóc trẻ bị nấm miệng. Nếu trẻ có các triệu chứng của nấm miệng, cha mẹ nên đưa trẻ đi khám bác sĩ để được chẩn đoán chính xác và điều trị kịp thời.
Quý khách có thắc mắc về vấn đề răng miệng, hãy liên hệ với Tâm Đức Smile ngay qua:
-
Hotline 19008040 - 0329851079 (Có sử dụng Zalo/Viber).




